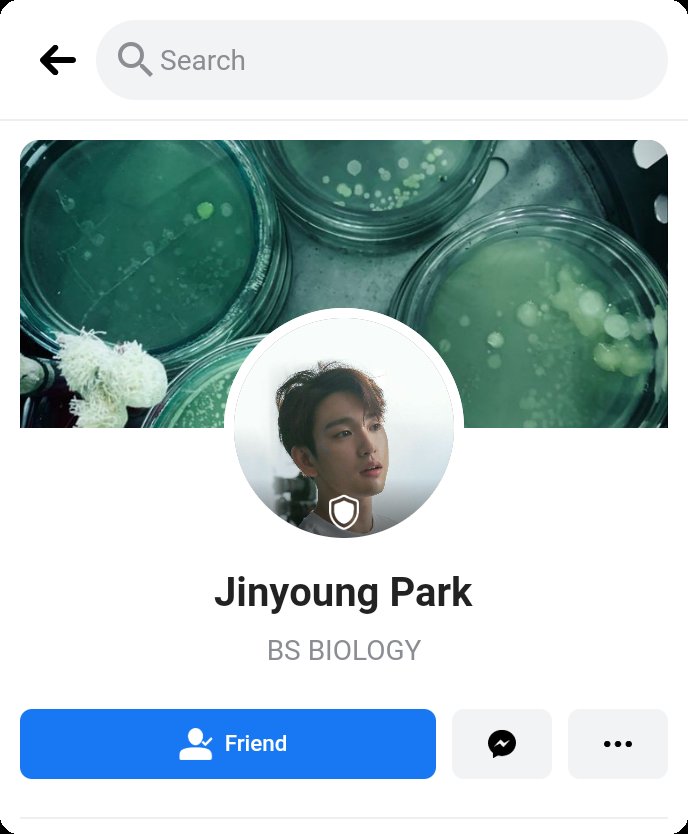

𝚃𝚒𝚖𝚎'𝚜 𝚄𝚙
Yeri has been crushing on Mark, their tenant, ever since she moved to her Tita's boarding house 4 years ago. She's been meaning to confess to him before he graduates but a pandemic strikes unexpectedly, and before she knew it, she already lost her chance.
#YeMa

Yeri has been crushing on Mark, their tenant, ever since she moved to her Tita's boarding house 4 years ago. She's been meaning to confess to him before he graduates but a pandemic strikes unexpectedly, and before she knew it, she already lost her chance.
#YeMa


A YeMa One-shot AU
- Traits and expressions of the characters DO NOT reflect who they are in real life lol
- Pictures aren't mine, unless stated, so credits to the rightful owners
- Purely for entertainment purposes only
- SocMed
- Traits and expressions of the characters DO NOT reflect who they are in real life lol
- Pictures aren't mine, unless stated, so credits to the rightful owners
- Purely for entertainment purposes only
- SocMed
Hi! First of all, thank you for reading this scam na au HAHAHAH Sorry kasi alam kong one shot naka-indicate tapos umabot ng 300+ tweets lol pero here it is my first au na natapos😂
Thank you so much for being patient with me and supporting this au, lahat ng likes, qrts/rts are very much appreciated💜
(Awkward ako so sorry if I don't know how to interact much😅)
(Awkward ako so sorry if I don't know how to interact much😅)
Yun na ba yun? At least for now, yes po. Marami rin akong tanong kaso wala pa rin siyang sagot kasi di pa din ako nagtanong char lang😂 If ever na may questions/comments/clarifications etc. you can leave a message here. Again, salamat ng marami💜
curiouscat.qa/anemonehun
curiouscat.qa/anemonehun
• • •
Missing some Tweet in this thread? You can try to
force a refresh